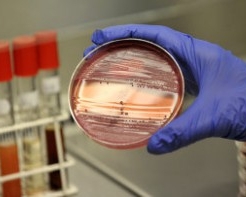

Число жертв особо опасного штамма E.сoli (кишечной палочки) в Европе, по последним данным, составило 50 человек. Ранее сообщалось о 47 жертвах.
В Германии зафиксировано 48 смертей, по одному человеку умерло от инфекции в Швеции и США. Всего в 16 странах выявлено свыше 4 тысяч случаев инфекции.
ВОЗ сообщает, что в Германии после вспышки инфекции в начале мая пострадали более 3,9 тысячи человек, более 800 из них перенесли особо тяжелую форму болезни, которая сопровождается осложнениями, известными как гемолитический уремический синдром HUS.
Количество новых случаев инфекции после пика, пришедшегося на 30 мая, стабильно снижается, сообщают немецкие власти.
Вспышка кишечной инфекции изначально была зафиксирована на севере Германии. Сначала предполагалось, что переносчиком опасных бактерий являются салатные огурцы из Испании, но это предположение не подтвердилось. Затем специалисты заявили, что источником инфекции могла стать ферма в Нижней Саксонии, которая поставляет на рынки страны пророщенную сою и другие злаки, используемые для приготовления салатов и вторых блюд.
В четверг специалисты Европейского центра по профилактике и борьбе с заболеваниями (ECDC) заявили, что зараженные бактерией E. coli пророщенные семена могли быть ввезены в Европу из Египта в 2009-2010 годах.
Инфекцию вызвала так называемая энтерогеморрагическая бактерия Escherichia coli (кишечная палочка). Бактерия E.coli часто присутствует в кишечнике людей и теплокровных животных. Большинство ее штаммов безвредны, но некоторые штаммы, такие, как EHEC, могут вызывать тяжелые болезни пищевого происхождения.
В начале июня, специалисты Европейского центра по контролю и профилактике заболеваний сообщили, что причиной заболеваний является редкий штамм E.сoli, принадлежащий к серотипу (вариативности внутри подвидов бактерий или вирусов) 0104: H4. Мутировавший штамм, из-за которого в Германии умирают люди, ранее не был известен, он устойчив ко многим антибиотикам.
Симптомы вызываемых бактериями EHEC болезней - кровавая диарея, жар и рвота. Большинство пациентов выздоравливают в течение десяти дней, но у незначительного числа пациентов (детей раннего возраста и пожилых людей) болезнь может принять тяжелую форму с угрозой для жизни.
Комментарии